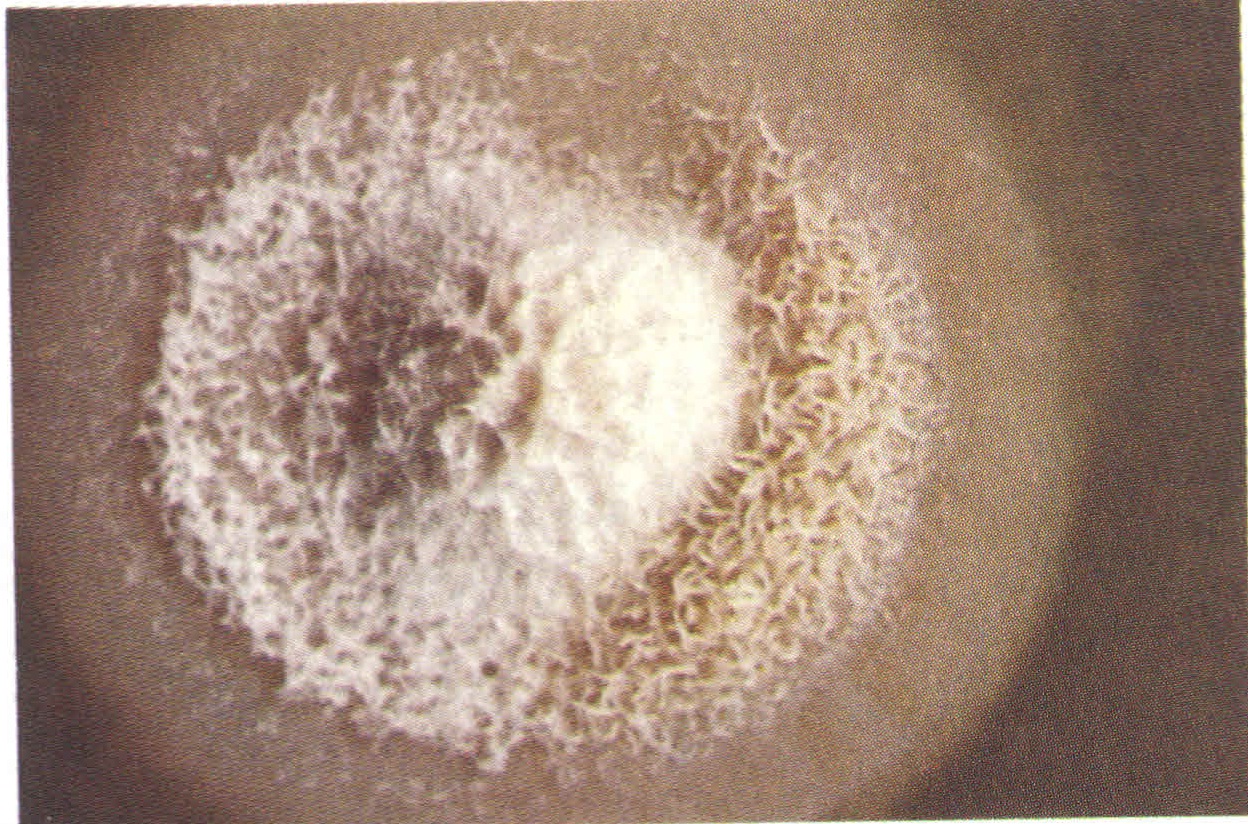

Güncel Laboratuvar Testleri
Sağlık Sistemimizle İlgili Yazılar
|
| Fungal Tanı Paneli |
| Yayınlanma Tarihi: |
|
|
|
|
|
SİSTEMİK (DERİN) MİKOZ İNFEKSİYONLARININ
Serolojik Tanısında Geniş
|
LABORATUVARLARIMIZDA AŞAĞIDAKİ FUNGAL ETKENLERİN
SEROLOJİK TANISI YAPILMAKTADIR
1. Cryptococcus antijen
2. Histoplasma antijen
3. Histoplasma antikor
4. Aspergillus (Galaktomannan) antijen
5. Aspergillus (A. fumigatus, A. niger, A. terrus, A. flavus) antikor
6. Blastomyces antikor
7. Coccidioides antikor
8. Candida antikor
9. Paracoccidioides antikor
10. Sporothrix antikor
|
 |
ÇALIŞMALAR İÇİN NE KADAR SERUM, BOS VEYA
DİĞER MATERYAL GEREKİR ?
|
Cryptococcus Antijen ve diğer kalitatif-semikantitatif çalışmaların her biri için en az 100 mikrolitre,
Diğer çalışmaların her biri için en az 0.5 ml materyal gereklidir.
En iyisi en az 1 ml, tercihen mümkünse daha fazla serum, BOS veya diğer materyal gönderilmelidir.
Serum steril olmalı, kontamine veya aşırı lipemik olmamalıdır. Eğer göndermede gecikme olacaksa, 2-80 C’ de 72 saat bekletilebilir. Daha uzun süreler için, -200 C altında bekletilmelidir. Tekrarlayan çözme ve dondurma işlemlerinden kaçınılmalıdır. Örnekler, laboratuvara serin ortamda gönderilmelidir.
SİSTEMİK (DERİN) MİKOZLARIN KLİNİK ÖNEMİ NEDİR ?
Sadece Cryptococcus infeksiyonu için bile şunları söyleyebiliriz:
• Cryptococcus infeksiyonundan ölen HIV/AIDS hasta sayısı dünyada her yıl yarım milyondan fazladır.
• Sahra-altı Afrika’da HIV/AIDS hastaları arasındaki ölüm nedenlerinde Cryptococcosis, Tuberkülozdan daha öndedir.
Aspergillus spp., Blastomyces dermatitidis, Candida spp., Coccidioides immitis, Coccidioides posadasii, Histoplasma capsulatum ve Paracoccidioides brasiliensis derin yerleşimli mikozların başlıca etkenleridir.
Bu etkenlerin tanısı, mikrobiyoloji laboratuvarı ve hekim için her zaman büyük güçlük oluşturmaktadır. Radyolojik olarak, sistemik fungusların oluşturduğu lezyonları, Candida hariç olmak üzere, Tüberküloz gibi diğer infeksiyoz lezyonlardan ve neoplazmlardan ayırmak oldukça güçtür. Semptomlar sıklıkla tipik olmayıp, pnömonileri, sarkoidozu, kanserleri veya diğer hastalıkları taklit edebilmektedirler. Tekrarlayan durumlarda bile, fungal etkenleri kültürle veya histopatolojiyle ortaya koymak güçtür. Candida ve Aspergillus hariç, üreme çok yavaştır ve 2-6 haftalık zaman almaktadır. Bu nedenle, tedaviye yön vermede seroloji önemli yer tutmaktadır.
Serolojik çalışmalarda, antijen ve antikor aramada enzim immuno assay (EIA), kompleman fiksasyon (CF), immuno difüzyon (ID), lateral flow assay (LFA) ve lateks aglutinasyon (LA) yöntemleri kullanılmaktadır.
|
 | İnvaziv aspergillosis (IA), allerjik bronkopulmoner aspergillosis (ABPA) ve aspergilloma formlarında görülmektedirler. Seroloji, ABPA ve aspergilloma tanısında yararlıdır. Bu infeksiyonlar, immunokompetan bireylerde antikor yükselmesiyle seyrederler. |
 | Aspergillomada % 90, ABPA’ da % 70 olgularda antikor yükselmesi görülmektedir. Immunosuprese bireylerde korelasyon bu denli paralel değildir. Uzun süreli antifungal veya kortikosteroid tedavisi alanlarda, bazı hastalarda negatif sonuç görülebilir. Referans antiserum kullanıldığı takdirde, Immun Difüzyon (ID) % 100 spesifiktir. |
|
BLASTOMYCOSIS
Solunum yolu, cilt lezyonları verebilir ve yayılabilir. Patogonomonik semptomlar ve spesifik radyolojik bulgular vermez.
Kültürle kanıtlanmış olgularda, seroloji % 80 oranda uyum göstermiştir. Pozitif sonuçlar, gecikmeksizin tedaviyi gerektirir. Antikor titresi, hastalığın aktivitesiyle paraleldir
|
 |
 |
CANDIDIASIS
Candida türleri, vücutta çeşitli yerlerde saprofit olarak da bulunabilirler, hastalık da oluşturabilirler. Geniş spektrumlu antibiyotikler, kortikosteroidler ve sitotoksik diğer ilaçlar, Candida infeksiyonlarının artışına neden olmaktadırlar. Erken tanı ve tedavi hayat kurtarıcıdır. Yüzeyel Candida infeksiyonlarında ID test serolojisi |
 |
pozitif sonuç vermemiştir. Sistemik Candida infeksiyonlarında pozitif seroloji önemlidir. Immunosuprese bireylerde, negatif sonuç hastalığı ekarte ettirmez. |
 |
COCCIDIOMYCOSIS
C. immitis daha sık görülmektedir. Akut olgularda titre yükselmektedir. Antikorlar, bazen bir yıla kadar ölçülebilmektedir. İnfeksiyondan sonraki ilk iki haftada, % 80 olguda ID test pozitif olabilmektedir. |
 |
 |
HISTOPLASMOSIS
M antijenine karşı daha erken, H antijenine karşı daha sonra antikor yanıtı oluşmaktadır. Pulmoner histoplasmosiste M yanıtı daha öndedir. Olguların % 85-94’ ünde serolojik yanıt vardır. Antikor titreleri tanıya yardımcıdır. Histoplasma capsulatum, en sıklıkla görülen tipidir. BOS’ ta pozitiflik, meningeal histoplasmosisi düşündürür. |
 |
 |
PARACOCCIDIOMYCOSIS
P. brasiliensis sık görülen ajandır. AIDS olgularında nispeten seyrektir. Antikor tespiti, tanıda önemlidir. Paracocccidiomycosis olgularında % 95-98 oranda antikor yanıtı görülmektedir. Pozitif sonuç, tanıda önemlidir. |
 |
KAYNAKLAR
1. Cox, M., G. Pesek, D. Phan, and G. Woods. 2008. Utility of a Histoplasma capsulatum Enzyme Immunoassay for Diagnosis of Disseminated Histoplasmosis and Correlation With Disease Activity. Arch. Pathol. Lab Med 132:1512.
2. Gomez, B. L., J. I. Figueroa, A. J. Hamilton, B. L. Ortiz, M. A. Robledo, A. Restrepo, and R. J. Hay. 1997. Development of a novel antigen detection test for histoplasmosis. J. Clin. Microbiol. 35:2618-2622
3. Kauffman, C. A. 2008. Diagnosis of histoplasmosis in immunosuppressed patients. Curr. Opin. Infect. Dis. 21:421-425.
4. Kauffman, C. A. 2007. Histoplasmosis: a clinical and laboratory update. Clin. Microbiol. Rev. 20:115-132
5. Wheat, J. 1994 Histoplasmosis: recognition and treatment. Clin. Infect. Dis. 19 Suppl 1:S19-S27
6. Yeo, S. F. And B. Wong. 2002. Current status of nonculture methods for diagnosis of invasive fungal infections. Clin. Microbiol. Rev. 15:465-484
7. Doering, T. L. 2009 How sweet it is! Cell wall biogenesis and polysaccharide capsule formation in Cryptococcus neofarmans. Anuu. Rev. Microbiol. 63:223-247
8. Goodman, J. S., L. Kaufman, and M. G. Koenig. 1971. Diagnosis of cryptoccoccal meningitisz. Value of immunologic detection of cryptococcal antigen. N. EngI. J. Med. 285:434-436.
9. Kozel, T. R. 1995b Virulence factors of Cryptococcus neoformans. Trends Microbiol. 3:295-299.
10. Lin, X. And j. Heitman. 2006. The biology of the Cryptococcus neoformans species complex. Annu. Rev. Microbiol. 60:69-105.
11. Lindsley, M. D., D. W. Warnock, and C. J. Morrison. 2006. Serological and Molecular Diagnosis of Fungal Infections, p. 569-605. In B. Detrick, R. G. Hamilton, and J. D. Folds (ed.), Manual of Molecular and Clinical Laboratory Immunology. ASM Pres, Qashington, D. C.
12. Park, B. J., K. A. Wannemuehler, B. J. Marston, N. Govender, P. G. Pappas, and T. M. Chiller. 2009. Estimation of the current global burden of cryptococcal meningitis among persons living with HIV/AIDS. AIDS 23:525-530
13. Zhou, Q. And W. J. Murphy. 2006. Immune response and immunotherapy to Cryptococcus infektions. Immunol. Res. 35:191-208.
14. Abrams, D. I., M. Robia, W. Blumenfeld, J. Simonson, M. B. Cohen, and W. K. Hadley. 19+84. Disseminated coccidioidomycosis in AIDS. N. Engl. J. Med. 310:986-987.
15. Antoniskis, D., R. A. Larsen, M. Akil, M. U. Rarick, and j. M. Leedom. 1990 Seronegative disseminated coccidioidomycosis in patients with HIV infection. AIDS 4:691-693
16. Bradsher, R. W. and P. G. Pappas. 1995. Detection of specific antibodies in human blastomycosis by enzyme immunoassay. South. Med. J. 88:1256-1259
17. Bronnimann, D. A., R. D. Adam, J. N. Galgiani, M. P. Habib, E. A. Petersen, B. Porter, and J. W.Bloom. 1987. Coccgdioidomycosis in the acquired immunodeficiency syndrome. Ann. İntern. Med. 106:372-379
18. Brummer, E., E. Castaneda, and A. Restrepo. 1993. Paracoccidioidomycosis.an update. Clin. Microbiol. Rev. 6:89-117.
19. Bullock, W. E. 1995. Histoplasma capsulatum, p. 2340-2353. In G. L. Mandell, J. Bennet, and R. Dolin (eds.), Principles and practice of infectious disease. Churchill Livingston, New York.
20. Fisher, M. C., B. Rannala, V. Chaturvedi, and J. W. Taylor. 2002. Disease surveillance in recombining pathogens: multilocus genotypes identify sources of human Coccidioides infections. Proc. Natl. Acad. Sci U.S.A 99:9067-9071.
21. Goldani, L. Z. And A. M. Sugar. 1995. Paracoccidioidomycosis and AIDS: an overview. Clin. Infect. Dis. 21:1275-1281
22. Kaufman, L. 1992. Laboratory methods fort he diagnosis and confirmation of systemic mycoses. Clin. Infec. Dis. 14 Suppl 1:S23-S29
23. Kaufman, L., J. A. Kovae, and E. Reis. 1997. Clinical immunomycology, p. 575-583. In N. Rose, E. De Macario, J. Folds, H. Lane, and R. Nakamura (eds.), Manual of clinical laboratory immunology. American Society for Microbiology, Washington, DC.
24. Reis, E., L. Kaufman, J. Kovacs, and M. Lindsley. 2002. Clinical XImmunomycology, p. 559-583. In N. Rose, R. Hamilton, and B. Detrick (eds.), Manual of Clinical Laboratory Immunology. ASM Pres, Washington, DC.
25. Zimmermann, C. R., S. M. Johnson, G. W. Martens, A. G. White, B. L. Zimmer, and D. Pappagianis. 1998. Protection against lethal murine coccidioidomycosis by a soluble vaccine from spherules. Infect. Immun. 66:2342-2345. td> |
|
Güncel Ortamdan Seçtiklerimiz
|